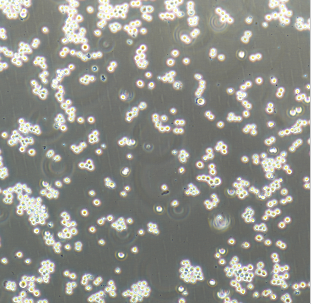
大鼠肝癌细胞RH35

大鼠肝癌细胞RH35,培养条件具体详情可以咨询我司客服
冻存条件 | 无血清冻存液(货号:C7001)。 |
传代方法 | 第一次建议1:2传代 | 传代情况 | 2天换液 |
备注 | 建议同时购买完培,同时购买非常优惠 |
细胞收到后处理
培养至良好状态后灌满完全培养液并封好瓶口是运输细胞的最好办法。收到细胞用75%酒精喷洒整个细胞瓶,消毒后放到超净台内严格无菌操作,将细胞瓶放入37℃、5%CO2的培养箱中静置3-4小时以稳定细胞状态后再做处理。显微镜观察细胞生长情况,并对细胞进行不同倍数拍照保存(最好40x,100x,200x各一张),前三天照片是重要售后依据,不提供照片默认收到状态良好。(换液后将瓶盖拧松)

大鼠肝癌细胞RH35,培养步骤
a、细胞传代:如果未超过80%汇合度时,将瓶装的完全培养液收集至离心管中,留5ml完全培养基,放入37℃、5%CO2孵箱培养;如果细胞密度超80%,即可进行传代培养,传代具体步骤如下:
1. 弃去培养上清,用不含钙、镁离子的PBS润洗细胞1-2次。
2. 添加0.25%胰蛋白酶消化液约1-2ml至培养瓶中,置于37℃培养箱中消化1-2min,然后在显微镜下观察细胞消化情况,若细胞大部分变圆并脱落,迅速拿回操作台,轻敲几下培养瓶后加5ml以上完全培养基终止消化。
3.轻轻吹打细胞,使之完全脱落后吸出,然后将悬液转移至15ml离心管中,在1000RPM条件下离心5分钟,弃去上清液,补加1-2mL完全培养基重悬。
4. 将细胞悬液按1:2的比例进行分瓶传代(两个T25瓶),补充新的完全培养基至5-8ml/瓶,最后放入到37℃、5%CO2的细胞培养箱中培养。
b、细胞冻存:
1、细胞生长至覆盖培养瓶的80%面积时,弃T25培养瓶中的培养液,用PBS清洗细胞一次;
2、添加0.25%胰蛋白酶消化液约1ml至培养瓶中,倒置显微镜下观察,待细胞回缩变圆后加入5ml完全培养液终止消化,再轻轻吹打细胞使之脱落,然后将悬液转移至15ml离心管中,1000rpm离心 5min;
3、 弃上清,沉淀细胞加入1ml的雅吉生物无血清冻存液(货号:C7001),混匀后加入冻存管中。
4、 将冻存细胞直接放入-80℃冰箱即可,如后期要将细胞转入液氮罐中,则需在-80℃冰箱 中存放24小时以上再转入液氮罐中。
C、细胞复苏:
1、从液氮中取出细胞冻存管(注意佩戴防护面具),快速将其置入 37℃水浴中解冻, 直至冻存管中无结晶,然后用75%的酒精擦拭冻存管外壁;
2、将冻存管中的细胞移至含 5ml 完全培养基的15ml离心管中,1000rpm离心5min;
3、弃上清,沉淀用5ml完全培养基重悬,接种至T25培养瓶,放于37℃,5%CO2细胞培养箱中培养;
4、第二天,换用新鲜完全培养基继续培养。
注意事项:有些细胞贴壁不牢,在运输过程中容易发生细胞脱落,这是正常现象。如脱离较多可将培养瓶所有培养液收集至离心管,1000rpm离心5min,收集上清作过渡培养(后期对比培养),沉淀加入胰酶1-2ml,轻轻吹打,重悬,消化1-2分钟后,加5ml完全培养基终止反应。再离心,弃上清,加1-2ml完全培养基重悬。然后按1:2比例进行分瓶传代(两个T25),补充新的完全培养基至5-8ml/瓶,最后放入37℃,5%CO2细胞培养箱中培养。
大鼠肝癌细胞RH35,售后条款:
1)细胞出现问题,可重发的情况有哪些?判定标准是什么?
1. 细胞运输途中遭遇的各种问题,细胞丢失、瓶身破损、培养液严重漏液等,重发;
2. 细胞污染问题,请在收到产品48小时内,给我们提出真实的实验结果,核实后重发;
3. 常温发货的细胞静置24小时后,干冰冻存发货的细胞复苏后24小时后,绝大多数细胞未存活,(需提供真实清晰的细胞状态照片),重发;
4. 干冰冻存发货的细胞复苏后24小时后或常温发货的细胞静置4小时候并且未开封,出现污染,重发;
5. 细胞活性问题,请在收到产品7天内给我们提出真实的实验结果,用台盼蓝染色法鉴定细胞活力,核实后予重发;
6. 细胞收到当天以及第2,3天请拍照,3天未告知的,视为产品合格。4-7天内出现问题有提供收到细胞前3天照片和细胞出现问题时照片以及细胞相关操作的详细步骤的,并跟技术人员沟通的,由技术人员判定为我方责任的,重发。技术人员判定为双方承担责任的由双方进行协商处理或者按合同价的50%收费重发。
2)细胞出现问题,不予以重发的情况有哪些?
1. 客户造成细胞污染,不重发;
2. 客户不正确操作致细胞状态不好,不重发;
3. 非本库推荐细胞培养体系致的细胞状态不好,不重发;
4. 细胞状态不好,未提供细胞培养前3天照片的,不重发;
5. 细胞培养时经其它处理的,不重发;
6. 细胞收到2天内,未告知,不重发;
欢迎新老客户咨询订购:大鼠肝癌细胞RH35
更多细胞可以咨询我司客服:
| GT1891C | YUMM17 | 小鼠黑色素瘤细胞YUMM1.7 | 3000 | DMEM/F12+10%胎牛血清+1%NEAA+1%P/S |
| GT1892C | MC38OVA | 小鼠结肠癌细胞-OVA鸡基因修饰MC38OVA | 6500 | DMEM+10%FBS+1%L-谷氨酰胺+1%NEAA+1%丙酮酸钠+1%HEPES+1%P/S |
| GT1893C | 15P1 | 小鼠睾丸上皮细胞15P1 | 2500 | DMEM+10%FBS+1%P/S |
| GT1894C | AtT20 | 小鼠垂体瘤细胞AtT20 | 2500 | 1640+10%FBS+1%P/S |
| GT1895C | cmt93 | 小鼠结直肠癌细胞cmt93 | 2500 | DMEM+10%FBS+1%P/S |
| GT1896C | L6565 | 小鼠白血病细胞L6565 | 2500 | 1640+10%FBS+1%P/S |
| GT1897C | CFSC8B | 大鼠永生型肝星状细胞CFSC8B | 1350 | DMEM+10%FBS+1%P/S贴壁 |
| GT1898C | AR42J | 大鼠胰腺外分泌腺肿瘤细胞AR42J | 1500 | F12K+20%FBS+1%P/S |
| GT1899C | INS1 | 大鼠胰岛细胞瘤细胞INS1 | 1500 | 1640+10%FBS+0.05mMβ-巯基乙醇+1%丙酮酸钠+1%P/S |
| GT1900C | RSC96 | 大鼠雪旺细胞RSC96 | 1350 | DMEM+10%FBS+1%P/S |
| GT1901C | A7r5 | 大鼠胸大动脉平滑肌细胞A7r5 | 1500 | DMEM(含NaHCO31.5g/L)+10%FBS+1%L-谷氨酰胺+1%P/S贴壁 |
| GT1902C | H9c2 | 大鼠心肌细胞H9c2 | 1500 | DMEM(含NaHCO31.5g/L)+10%FBS+1%P/S |
| GT1903C | IEC6 | 大鼠小肠隐窝上皮细胞IEC6 | 1500 | DMEM(含NaHCO31.5g/L)+10%FBS+1%P/S+0.01mg/ml胰岛素贴壁 |
| GT1904C | RBL2H3 | 大鼠嗜碱性白血病细胞RBL2H3 | 1500 | MEM+15%FBS+1%P/S贴壁 |
| GT1905C | HBZY1 | 大鼠肾小球系膜细胞HBZY1武汉期货 | 2000 | DMEM+10%FBS+1%P/S |
| GT1906C | NRK52E | 大鼠肾细胞NRK52E | 1800 | DMEM(含NaHCO31.5g/L)+5%FBS+1%P/S贴壁 |
| GT1907C | OLN93 | 大鼠少突胶质前体细胞系OLN93 | 1350 | DMEM+10%FBS+1%P/S |
| GT1908C | ADB106 | 大鼠乳腺癌细胞ADB106 | 1350 | DMEM+10%FBS+1%P/S |
| GT1909C | CTX | 大鼠脑星形胶质细胞CTX | 1350 | DMEM+10%FBS+1%P/S贴壁 |
| GT1910C | CTXTNA2 | 大鼠脑星形胶质细胞CTXTNA2 | 1350 | DMEM+10%FBS+1%P/S贴壁 |
| GT1911C | DITNC1 | 大鼠脑间质细胞DITNC1 | 1500 | DMEM+10%FBS+1%P/S贴壁 |
| GT1912C | 9LlacZ | 大鼠胶质肉瘤细胞9LlacZ | 1500 | DMEM+10%FBS+1%P/S |
| GT1913C | C6 | 大鼠胶质瘤细胞C6 | 1500 | F12K+2.5%FBS+15HS+1%P/S |
| GT1914C | VSC41 | 大鼠脊髓前角运动神经元瘤VSC4.1 | 1500 | DMEM+10%FBS+1%P/S |
| GT1915C | IEC18 | 大鼠回肠细胞IEC18 | 1500 | DMEM(含NaHCO31.5g/L)+5%FBS+1%P/S+0.01mg/ml胰岛素贴壁 |
| GT1916C | UMR106 | 大鼠骨肉瘤细胞UMR106 | 1500 | DMEM+10%FBS+1%PS |
| GT1917C | HSCT6 | 大鼠肝星形细胞HSCT6 | 1350 | DMEM+10%FBS+1%P/S |
| GT1918C | NRK49F | 大鼠肾细胞正常NRK49F | 1500 | DMEM+10%FBS+1%P/S |
| GT1919C | BRL | 大鼠肝细胞BRL | 1350 | DMEM+10%FBS+1%P/S贴壁 |
| GT1920C | BRL3A | 大鼠肝细胞BRL3A | 1350 | MEM+10%FBS+1%P/S贴壁 |
| GT1921C | CBRH7919 | 大鼠肝癌细胞CBRH7919 | 1500 | 1640+20%FBS+1%P/S |
| GT1922C | H4IIEC3 | 大鼠肝癌细胞H4IIEC3 | 1800 | DMEM+20%马血清+5%FBS+1%P/S |
| GT1923C | RH35 | 大鼠肝癌细胞RH35 | 1350 | DMEM+10%FBS+1%P/S |
| GT1924C | NR8383 | 大鼠肺泡巨噬细胞NR8383 | 1800 | F12K+15%FBS+1%L-谷氨酰胺+1%P/S悬浮和贴壁混合 |
| GT1925C | GH3 | 大鼠垂体瘤细胞GH3 | 1500 | F12K+2.5%FBS+15%HS(马血清)+1%P/S |
| GT1926C | L6 | 大鼠成肌细胞L6 | 1350 | DMEM+10%FBS+1%P/S |
| GT1927C | DRG | 大鼠背根神经节细胞DRG | 1350 | DMEM+10%FBS+1%P/S |
| GT1928C | RINm5f | 大鼠β胰岛素瘤细胞RINm5f | 1500 | 1640+10%FBS+1%P/S贴壁 |
| GT1929C | RLE6TN | 大鼠Ⅱ型肺泡上皮细胞RLE6TN | 1800 | 准备F12培养基;添加ITS(10ug/mL胰岛素;转铁蛋白5.5ug/mL;5ng/mL硒)1%,EGF5ng/mL,优质胎牛血清,10%;双抗,1%。 |
| GT1930C | CA77 | 大鼠甲状腺髓样癌细胞CA77 | 7500 | DMEM/F12+10%FBS+1%P/S贴壁 |
| GT1931C | IR983F | 大鼠骨髓瘤细胞IR983F | 2000 | 1640+10%FBS+1%P/S悬浮 |
| GT1932C | SHZ88 | 大鼠乳腺癌细胞SHZ88 | 2500 | DMEM+10%FBS+1%P/S贴壁 |
| GT1933C | USMC | 大鼠血管平滑肌细胞USMC | 1500 | DMEM+10%FBS+10ng/ml成纤维因子贴壁 |
| GT1934C | MMQ | 大鼠垂体瘤细胞MMQ | 2000 | 1640+20%FBS悬浮 |